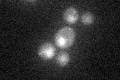
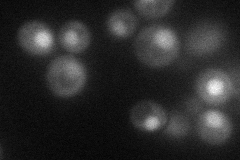
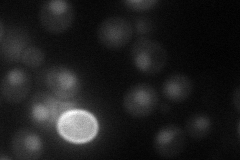
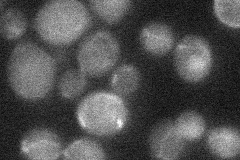
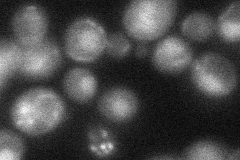
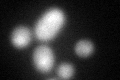
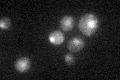

View description
Delta 2-isopentenyl pyrophosphate:tRNA isopentenyl transferase, required for biosynthesis of the modified base isopentenyladenosine in mitochondrial and cytoplasmic tRNAs; gene is nuclear and encodes two isozymic forms
Localization:
Intensity:
Fold change:
Significance:
-
C’ GFP library in SD
nucleus31.62 -
N' NOP1pr-GFP in SD
nucleus38.1472 -
N' TEF2pr-mCherry in SD
nucleus43.1714 -
N' NATIVEpr-GFP in SD
below threshold21.8531 -
N' TEF2pr-VC and Cyto-VN in SD
nucleus38.3902 -
C’ GFP library in SD+DTT
nucleus31.621No -
C’ GFP library in SD+H2O2

nucleus32.521.02No -
C’ GFP library in Starvation Media
nucleus30.510.96No -
C’ GFP library on the background of Pup2-DaMP

nucleus -
C’ GFP library on the background of CCT mutant

nucleus30.61340.968012No
